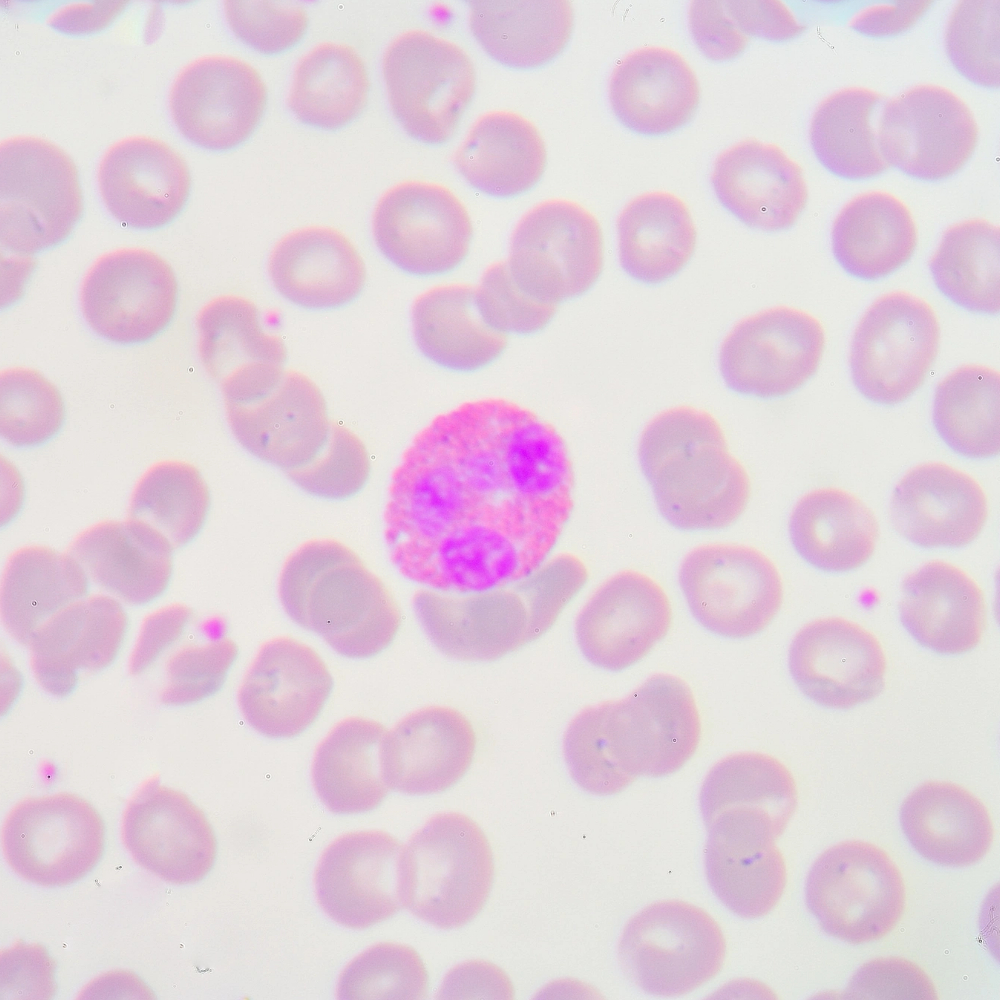
Renforcer le système immunitaire

Massage Tui Na avec Fanny Bellon
Massage Tui Na avec Fanny Bellon
Le massage Tui Na avec Fanny Bellon s’inscrit dans la tradition énergétique chinoise, centrée sur la circulation harmonieuse du Qi — l’énergie vitale. À travers des pressions, des étirements et des mouvements précis, il agit en profondeur sur les tensions musculaires, les blocages et la fatigue accumulée.
Présente entre Annemasse et la Suisse, Fanny propose des séances personnalisées selon vos besoins : détente, revitalisation ou accompagnement thérapeutique.
Chaque séance de Tui Na devient un véritable rééquilibrage du corps et de l’esprit, favorisant la vitalité, la clarté mentale et une sensation durable d’ancrage.
Tarifs
- 45mn / 45€
- 1h15 / 75€
- 1h30 / 90€ avec soin énergétique bain sonore avec bol tibétain
Massage Tui Na avec Fanny Bellon
Massage Tui Na avec Fanny Bellon
Le massage Tui Na avec Fanny Bellon s’inscrit dans la tradition énergétique chinoise, centrée sur la circulation harmonieuse du Qi — l’énergie vitale. À travers des pressions, des étirements et des mouvements précis, il agit en profondeur sur les tensions musculaires, les blocages et la fatigue accumulée.
Présente entre Annemasse et la Suisse, Fanny propose des séances personnalisées selon vos besoins : détente, revitalisation ou accompagnement thérapeutique.
Chaque séance de Tui Na devient un véritable rééquilibrage du corps et de l’esprit, favorisant la vitalité, la clarté mentale et une sensation durable d’ancrage.
Les bienfaits du « Massage Tui Na » face à vos maux du quotidien
Le massage Tui Na agit sur le corps comme sur l’énergie vitale. Héritée de la médecine traditionnelle chinoise, cette pratique stimule les points d’acupuncture, libère les tensions et favorise la circulation harmonieuse du Qi.
Grâce à des pressions ciblées et des manipulations adaptées, elle contribue à soulager les douleurs musculaires, améliorer la digestion, renforcer l’immunité et apaiser le mental.
Voici quelques situations dans lesquelles le Tui Na peut vous aider à retrouver équilibre et vitalité.
Comment se déroule une séance de massage Tui Na avec Fanny Bellon ?
Le massage Tui Na, pratiqué par Fanny Bellon à Annemasse et en Suisse, est un soin à la fois énergétique et corporel, issu de la médecine traditionnelle chinoise.
Chaque séance est personnalisée selon vos besoins : tensions, fatigue, douleurs, stress ou simple envie de rééquilibrage.
Fanny détermine ensuite les méridiens à travailler pour rétablir la circulation énergétique (le Qi) et apaiser les blocages.
À l’aide de pressions, frictions, étirements et mobilisations, Fanny agit sur les muscles, les articulations et les points énergétiques.
Le corps retrouve peu à peu chaleur, souplesse et fluidité.
L’énergie se remet à circuler librement, dissipant les tensions physiques et mentales.
Beaucoup ressentent une détente profonde, parfois accompagnée d’une sensation de légèreté ou de clarté intérieure.
Vous reprenez contact avec vos sensations, souvent dans un état de vitalité paisible.
Le massage Tui Na n’est pas qu’un soin du corps : c’est une réharmonisation complète de l’être, où chaque geste invite le corps à se souvenir de son équilibre naturel.